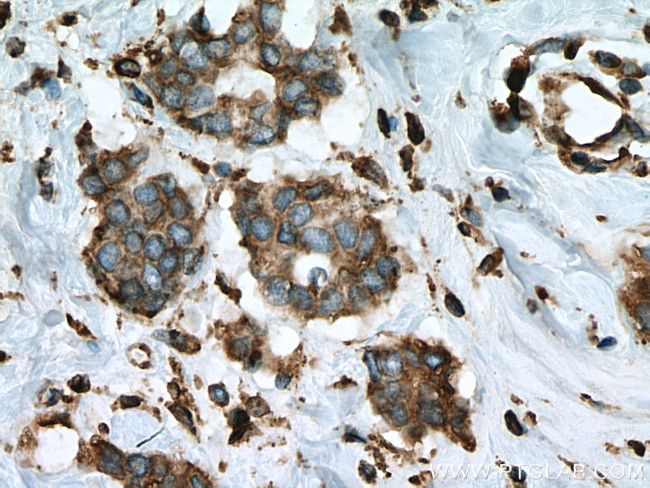
ERP44 Antibody in Immunohistochemistry (Paraffin) (IHC (P))

Search
Proteintech
ERP44 Monoclonal Antibody (3A2C1)
{{$productOrderCtrl.translations['antibody.pdp.commerceCard.promotion.promotions']}}
{{$productOrderCtrl.translations['antibody.pdp.commerceCard.promotion.viewpromo']}}
{{$productOrderCtrl.translations['antibody.pdp.commerceCard.promotion.promocode']}}: {{promo.promoCode}} {{promo.promoTitle}} {{promo.promoDescription}}. {{$productOrderCtrl.translations['antibody.pdp.commerceCard.promotion.learnmore']}}
产品信息
67426-1-IG
种属反应
宿主/亚型
分类
类型
克隆号
抗原
偶联物
形式
浓度
纯化类型
保存液
内含物
保存条件
运输条件
产品详细信息
Aliquoting is unnecessary for -20°C storage.
靶标信息
Mediates thiol-dependent retention in the early secretory pathway, forming mixed disulfides with substrate proteins through its conserved CRFS motif. Inhibits the calcium channel activity of ITPR1. May have a role in the control of oxidative protein folding in the endoplasmic reticulum. Required to retain ERO1L and ERO1LB in the endoplasmic reticulum.
仅用于科研。不用于诊断过程。未经明确授权不得转售。
篇参考文献 (0)
生物信息学
蛋白别名: Endoplasmic reticulum resident protein 44; endoplasmic reticulum resident protein 44 kDa; endoplasmic reticulum resident protein 44kDa; endoplasmic reticulum resident protein ERp44; ER protein 44; OTTHUMP00000063799; protein disulfide isomerase family A, member 10; thioredoxin domain containing 4 (endoplasmic reticulum); Thioredoxin domain-containing protein 4
基因别名: 1110001E24Rik; AI849526; AL033348; BWK4; ERP44; KIAA0573; PDIA10; TXNDC4; UNQ532/PRO1075
UniProt ID: (Human) Q9BS26, (Mouse) Q9D1Q6
Entrez Gene ID: (Human) 23071, (Mouse) 76299, (Rat) 298066